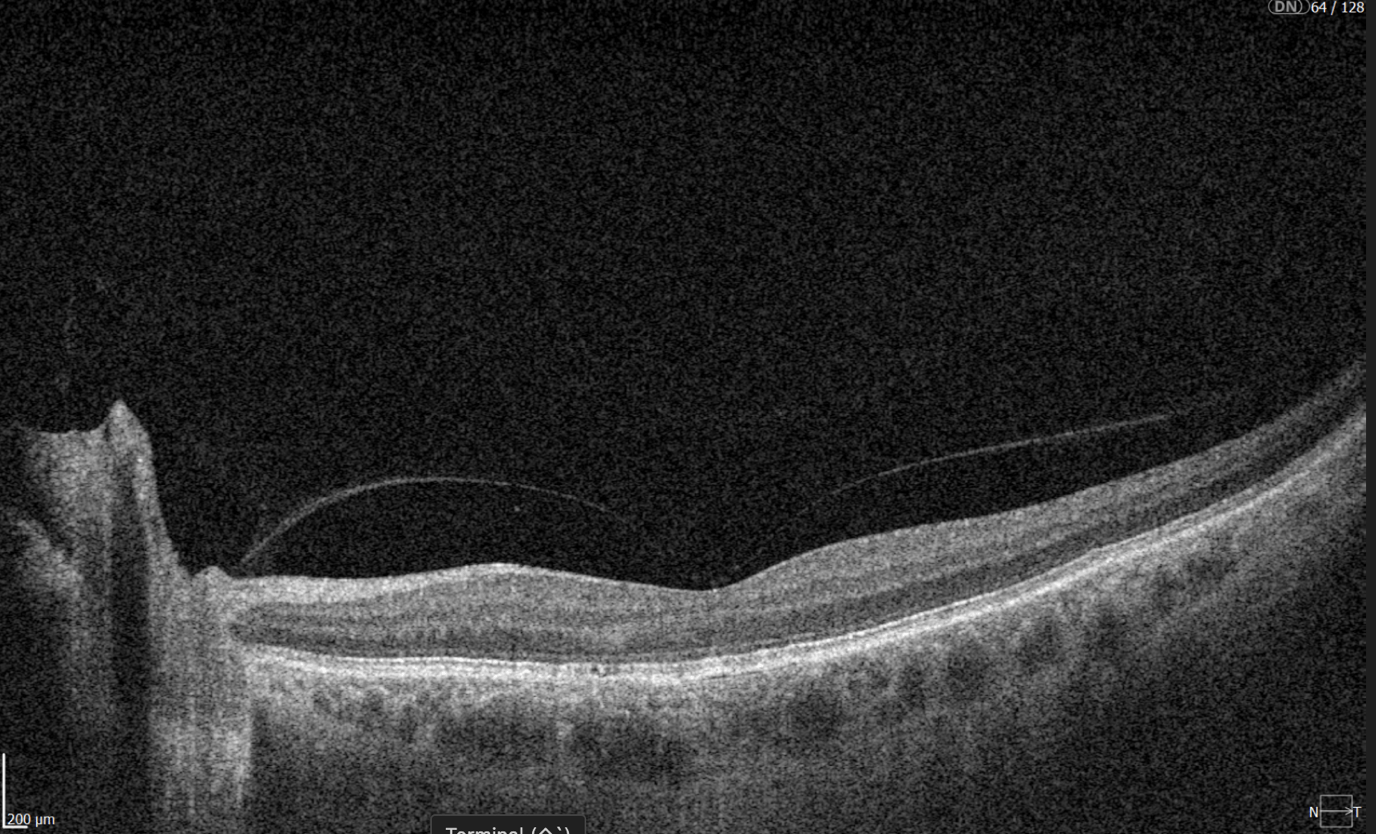
3d wide glaucoma report

Recently Posted
-
Key Trends in Ophthalmology and Optometry in 2026
Maria Znamenska
3 min.Introduction
The year 2026 in ophthalmology will not be defined by a single “major breakthrough,” but rather by the maturation of several directions whose discoveries and innovations are now transitioning into everyday clinical practice. While just a few years ago innovations were often perceived as isolated technologies far removed from real-world care (a new drug, device, or piece of equipment), today entire ecosystems are being formed: from early detection to long-term monitoring, from the ophthalmologist’s office to optometric screening, from a single consultation to a longitudinal patient journey supported by digital tools.
The core logic of 2026 is a shift from reactive to proactive ophthalmology. Increasingly, the goal is to prevent disease at the stage of risk-factor modification, intervene in the earliest pathological changes, and track preclinical markers. This shift is visible across several dimensions: the growing role of telemedicine and portable diagnostics; autonomous AI becoming a public health tool; and oculomics, which enables ocular image analysis to serve as a source of early biomarkers for systemic conditions. At the same time, the treatment paradigm is evolving: where repeated procedures once dominated (for example, frequent intravitreal injections), 2026 brings a move toward extended-duration regimens, implant-based drug delivery platforms, and disease control with fewer clinic visits.
Another important axis is the alignment of patient expectations. Some new approaches (for example, in the management of dry AMD and geographic atrophy) do not promise to “restore vision,” but rather to buy time—slowing structural retinal damage and functional vision loss. As a result, in 2026, risk–benefit communication and shared decision-making become almost as important as the choice of molecule or device itself.
Below, we outline the key eye care trends of 2026: what is changing, why it matters, and how it will shape ophthalmic and optometric practice.
1. New Approaches to Treatment
1.1. Geographic Atrophy (GA): The Introduction of Active Treatment in eye care trends 2026
1.1.1. Injectable Therapies as Ophthalmology Trends 2026
Following the development of injectable therapies for geographic atrophy, clinical practice is entering a “second wave” phase—where the main questions are no longer whether therapy is possible for a disease historically considered untreatable, but how that therapy should be practically implemented. In 2026, the focus will be on patient selection, treatment initiation, dosing frequency and duration, as well as monitoring.
Currently, the FDA has approved the following injectable therapies for GA:
- Izervay (avacincaptad pegol) — a C5 complement inhibitor.
- Syfovre (pegcetacoplan) — a C3 complement inhibitor.
Their mechanism of action involves reducing chronic inflammation and cellular damage in the retina and—most importantly—slowing the rate of GA lesion expansion.
Because most available data focus on slowing atrophy progression (an anatomical endpoint) rather than guaranteed improvements in visual acuity, properly managing patient expectations becomes particularly critical in 2026. Clear discussions about therapeutic goals and limitations are emphasized in review publications addressing the first approved GA treatments.
1.1.2. Multiwavelength Photobiomodulation
Multiwavelength photobiomodulation is one of the most promising emerging approaches aimed at halting or slowing the progression of dry AMD through modulation of mitochondrial activity. The use of specific wavelengths (red and near-infrared light, approximately 590–850 nm) may reduce oxidative stress in retinal cells, inflammation, and apoptosis of retinal pigment epithelium cells.
Its appeal is clear: a non-invasive procedure with significantly better acceptability for some patients compared with regular injections.
Until recently, its effectiveness remained debated, with studies showing only temporary functional improvement and reduction in drusen volume. At ARVO 2025, updated results from the LIGHTSITE III study demonstrated that photobiomodulation can significantly slow visual acuity decline and reduce the rate of GA expansion.
In 2025, the FDA approved photobiomodulation for AMD, creating strong prospects for broader clinical adoption in 2026.
The 2026 trend is correct positioning and stratification:
- Use of photobiomodulation based on clear indications for specific dry AMD stages and patient profiles.
- Transparent communication of expectations, with goals focused on functional support and slowing GA progression rather than guaranteed vision restoration.
1.2. Extended Anti-VEGF Treatment Regimens
Another major trend is the shift toward regimens with reduced injection frequency. This is not merely about comfort, but primarily about preventing missed visits: patients with AMD and diabetic retinopathy with DME often fall out of treatment due to visit burden. Thus, 2026 reinforces the principle that treatment must be effective in real-world conditions, not only under ideal adherence.
The ranibizumab port delivery system (Susvimo, Port Delivery System) has become emblematic of this trend. In 2025, the FDA also approved Susvimo for the treatment of diabetic retinopathy.
1.3. Gene Therapy for Macular Telangiectasia Type 2 (MacTel 2)
MacTel 2 is a chronic, progressive neurodegenerative retinal disease that previously lacked active treatment.
In 2025, the first implantation of ENCELTO (revakinagene taroretcel)—the first and currently only FDA-approved gene therapy for MacTel 2—was performed in the United States. ENCELTO enables a shift from observation to active intervention, with the potential to preserve visual function in early-stage patients.
The device is based on encapsulated cell therapy technology: a capsule containing genetically modified cells that continuously secrete recombinant human ciliary neurotrophic factor (CNTF), acting as a neuroprotective agent that slows photoreceptor degeneration.
In 2026, the focus will move from “innovation storytelling” to routine clinical implementation, including defining early selection criteria, monitoring protocols (OCT biomarkers, functional testing), and accumulating real-world long-term data on photoreceptor preservation and visual function.
1.4. Gene Therapy for Neovascular AMD: Closest to Real Transformation
For neovascular AMD, gene therapy remains one of the most anticipated eye care trends 2026 directions, as it has the potential to fundamentally change treatment logic—from repeated injections to a single vector administration enabling long-term therapeutic protein expression. Reviews published in 2025 highlight active programs such as RGX-314, ADVM-022 (Ixo-vec), 4D-150, and others.
In 2026, the key questions shift from “does it work?” to “how does it work across different patient groups?” including:
- Stability and duration of expression;
- Inflammatory and immune response profiles;
- Need for supplemental anti-VEGF therapy;
- Patient selection criteria;
Injection centers and post-procedure monitoring standards.
2. Oculomics: The Eye as a “Window to the Body” and a Source of Digital Biomarkers
Oculomics is one of the most compelling trends of 2026, as it reshapes ophthalmology’s role within medicine as a whole. The concept is simple: the eye is the only structure where microvasculature, neurons, and signs of metabolic and inflammatory processes can be visualized non-invasively at high resolution. As a result, fundus and OCT/OCTA data may serve as biomarkers for systemic conditions—from cardiovascular risk to neurodegenerative diseases.
In contemporary research, oculomics is described as an approach that uses retinal images to assess systemic risks and conditions, with potential scalability for screening. In 2026, this “scale” becomes critical: data may originate not only from ophthalmology clinics, but also from optometric practices, mobile screening programs, and telemedicine.
What truly changes in 2026:
- A transition from “interesting correlations” to clinical utility, with models expected to demonstrate actionable impact on patient management.
- Data verification and management of false-positive risk, including the communication of systemic risk to patients.
- Integration with AI, as multidimensional patterns often exceed human interpretive capacity.
A major risk in 2026 is over-marketing, reinforcing the need for externally validated models with clear clinical context that do not generate unnecessary “medical noise.”
3. AI Technologies: From Decision Support to Autonomous Screening and Managed Patient Pathways

3.1. Autonomous Diabetic Retinopathy Screening as a Scalable Standard
In 2026, diabetic retinopathy remains the most studied use case for autonomous AI. In the United States, three FDA-approved autonomous DR screening systems are already described (LumineticsCore/IDx-DR, EyeArt, AEYE-DS). This positions AI as a practical tool capable of influencing large-scale screening programs, particularly in primary care, endocrinology clinics, and mobile settings.
The FDA approval of AEYE-DS as a fully autonomous solution (portable camera plus algorithm) underscores that in 2026, AI increasingly “works where the patient is,” not only where an ophthalmologist is present.
3.2. 2026 as the Year of Integration
Successful projects in 2026 will be distinguished by:
- Image quality standards and quality control;
- Clear referral rules and urgency levels;
- Mechanisms to ensure patient follow-through (scheduling, reminders, visit tracking);
- Transparent documentation for clinicians, patients, and audit purposes.
3.3. AI as “Invisible Infrastructure”
In 2026, AI increasingly functions as invisible infrastructure: highlighting high-risk cases, prioritizing queues, generating structured reports, and standardizing interpretation. The impact is reduced variability, faster routing, and fewer missed cases.
4. Telemedicine: From Video Calls to Retinal Screening and Remote Management
By 2026, telemedicine in ophthalmology is no longer synonymous with video consultations. Its foundation is tele-imaging: transmission and assessment of retinal images (fundus photos, sometimes OCT) with structured referral protocols.
At the same time, limitations become more openly discussed. Certain conditions and components of assessment may be less accurately captured remotely, requiring clear protocols to define which patients can be managed remotely and which require in-person examination.
The 2026 trend is a shift from “tool” to “pathway”:
- Tele-screening as the first step;
- Automated or semi-automated reporting;
- Referral and follow-up control;
Remote reassessment for ongoing risk monitoring.
5. New Devices and Portable Diagnostics: Closer, Faster, More Scalable Care
5.1. Portable Diagnostics as the Foundation of Coverage
Portable fundus cameras and compact diagnostic systems represent one of the most practical changes of 2026. Their value lies not only in technology, but in enabling large-scale screening in locations without full ophthalmic infrastructure.
Synergy with autonomous AI (such as AEYE-DS) is especially strong here, supporting new partnership models:
- Endocrinology and primary care clinics;
- Optical stores and optometric practices;
- Mobile programs for workplaces or regions.
5.2. Devices Deliver Value Only with Quality Protocols
Success depends not just on acquiring devices, but on defined protocols:
- Staff training in image acquisition;
- Minimum quality criteria;
- Retake rules;
- Handling ungradable cases.
In 2026, image quality becomes decisive, as AI and telemedicine depend on it.
5.3. Home and Remote Monitoring for Extended Treatment Regimens as eye care trends 2026
As treatment intervals lengthen, the risk of between-visit deterioration increases. Thus, 2026 strengthens the role of:
- Home functional monitoring;
- Digital questionnaires and symptom trackers;
Remote checkpoints signaling the need for earlier recall.
6. 2026 as the Year of Standardized Myopia Control and Greater Risk Awareness
By 2026, myopia control is no longer debated but formalized, grounded in consensus documents and systematic reviews. Myopia is increasingly recognized as a chronic disease with stages, phenotypes, and potentially blinding complications.
Implications for practice:
- Focus on preventing progression to high myopia.
- Combined strategies integrating behavioral, optical, and pharmacologic interventions with monitoring.
- A shared language between optometrists and ophthalmologists, with coordinated patient pathways.
- Support from AI and telemedicine for risk detection and personalized care.
Myopia control in 2026 becomes a structured, long-term risk-reduction process.
7. Optogenetics: Expanding the Evidence Horizon in Inherited Retinal Degenerations
In 2026, optogenetics moves beyond concept into longer-term observation. Publications from 2025 highlight functional stabilization or improvement in retinitis pigmentosa, emphasizing pragmatic success criteria.
For patients with severe vision loss, meaningful outcomes extend beyond visual acuity charts to spatial orientation, object recognition, and contrast sensitivity. In 2026, discussions increasingly focus on realistic endpoints and honest communication of limitations.
8. Less Invasive Interventions and Patient Comfort as Components of Clinical Effectiveness
Another key eye care trends 2026 is less traumatic technology that preserves efficacy while improving patient experience. A notable example is the FDA approval of Epioxa (epi-on) for keratoconus in 2025, preserving corneal epithelium and potentially reducing pain and recovery time.
This trend spans refractive surgery, ocular surface disease, and chronic condition management, reinforcing that patient experience is integral to adherence and clinical outcomes.
Conclusion
The ophthalmology trends 2026 clearly demonstrate that ophthalmology and optometry are entering a phase of mature transformation, where success is driven not by isolated innovations but by their integration into coherent clinical pathways. The focus is shifting from treating consequences to early detection, slowing progression, and long-term management of chronic eye disease.
Active treatment of geographic atrophy, photobiomodulation, extended anti-VEGF regimens, and the emergence of gene therapies for MacTel 2 and neovascular AMD fundamentally reshape patient management—from observation or frequent procedures to strategies aimed at preserving retinal structure and function with minimal procedural burden. These approaches require careful patient stratification and responsible expectation management, as the goal increasingly becomes slowing neurodegeneration rather than restoring vision.
At the diagnostic level, 2026 reinforces decentralization: portable devices, telemedicine, and autonomous AI bring screening closer to patients and enable coverage of much broader populations. Oculomics and AI transform ocular images into sources of digital biomarkers that may influence not only ophthalmic but also general clinical management. At the same time, it becomes clear that technological value is defined not by algorithms or devices, but by data quality, model validation, and clearly structured patient pathways—from screening to treatment.
-
Diabetic Retinopathy Screening and Treatment: a Complete Guide
Maria Znamenska
5 minDiabetic retinopathy screening and treatment: a complete guide
Table of Contents
- What are the diabetic retinopathy screening methods?
- Fundus images in DR screening
- Can OCT detect diabetic retinopathy?
- What does diabetic retinopathy look like on OCT?
- What is optimal diabetic retinopathy screening frequency?
- What is the best treatment for diabetic retinopathy?
- Diabetic retinopathy management: key takeaways
Diabetic retinopathy (DR) remains the leading cause of irreversible vision loss among working-age adults worldwide. According to the International Diabetes Federation (IDF), one in three patients with diabetes shows signs of DR, and 10% develop diabetic macular edema (DME). Early diagnosis, systematic screening, and individualized monitoring are essential to prevent vision loss.
What are the diabetic retinopathy screening methods?
Modern methods of DR screening include:
- Telemedicine platforms – enable automated transmission of fundus images
- Mobile fundus cameras – Wi-Fi–enabled devices for field examinations
- Smartphone-based platforms – use specialized lenses for retinal imaging
- Optical coherence tomography (OCT) – used to detect early retinal changes and diabetic macular edema, complementing fundus photography
- AI-based systems – solutions for automated image analysis for fundus and OCT
In practice, these methods are often combined. For example, patients may undergo fundus photography, after which images are sent to telemedicine centres and analysed by AI algorithms. More complex cases are then referred to ophthalmologists.
DR screening is frequently incorporated into annual diabetes check-ups conducted by primary care physicians trained in basic fundus photography. This approach, already successfully implemented in several EU countries, has reduced the incidence of severe DR.
Innovations in DR screening have broadened access for rural residents, older adults, and individuals with limited mobility. Integration into national e-health systems enables automated reminders and electronic medical record linkage, incorporating laboratory data (HbA1c, blood pressure) alongside retinal images.
Fundus images in DR screening
Fundus photography is the optimal primary screening method due to its high diagnostic yield, cost-efficiency, simplicity, and ability to integrate with AI and telemedicine solutions.
It enables detection of microaneurysms, hemorrhages, exudates, and neovascularization, often before symptoms arise. National screening programs rely heavily on digital fundus imaging, which, when combined with AI, provides an efficient platform for mass DR detection.
Advances in fundus imaging for diabetic retinopathy have improved efficiency. Modern non-mydriatic cameras deliver high-quality images without pupil dilation, while automated image analysis supports rapid identification of suspicious cases. Cloud storage and telemedicine platforms facilitate remote evaluation, increasing coverage in regions with limited ophthalmology services.
Next-generation wide-field cameras further enhance detection by capturing peripheral pathology. Some devices also generate automated annotations, reporting lesion type, DR stage, and DME presence, thereby standardizing interpretation and expediting clinical decision-making.

Diabetic retinopathy detection from fundus images Can OCT detect diabetic retinopathy?
Yes. OCT can detect early structural changes in the retina and is increasingly used to complement standard diabetic retinopathy screening.
- Role in DR screening – While not a primary screening tool, OCT is now widely applied alongside fundus photography. It is especially valuable for detecting early diabetic macular edema (DME) and subtle morphological changes in the central retina not visible during ophthalmoscopy.
- High-resolution imaging – OCT visualizes changes such as photoreceptor layer disruption, subclinical intraretinal fluid, neurosensory retinal thickening, and foveal edema. These findings often appear before clinically significant macular edema.
- Differential diagnosis – OCT also helps identify other causes of vision loss in diabetic patients, for example, ruling out age-related macular degeneration.
- Clinical evidence – Studies confirm that combining OCT with fundus photography increases diagnostic accuracy for DME. Experts therefore recommend this approach for patients with long-standing diabetes, poor glycemic control, or vision complaints.
What does diabetic retinopathy look like on OCT?
On OCT, diabetic retinopathy (DR) can appear as a combination of retinal structural damage, fluid accumulation, and microvascular changes that may not be visible on fundus photography.
Typical OCT findings in DR include:
- Photoreceptor damage – loss of outer retinal layers, especially the ellipsoid zone
- Intraretinal hyperreflective foci, hard exudates
- Microaneurysms – visible as small, round changes within the retina
- Retinal thickness changes and neuroepithelial layer atrophy
- Diabetic macular edema – with intraretinal hyporeflective cystoid spaces and neuroepithelial swelling
- Subretinal fluid – resulting from increased vascular permeability
- DRIL – disorganization of inner retinal layers, associated with poor prognosis
- Epiretinal membranes – potential precursors to retinal detachment
Advanced findings
OCT can also reveal proliferative changes and tractional zones, which may progress to tractional retinal detachment.OCTA insights
Beyond structural analysis, OCT angiography (OCTA) allows visualization of retinal microvascular changes without the contrast injection. OCTA helps identify areas of neovascularization, capillary network disruption, and the degree of macular ischemia.
Diabetic retinopathy (hyperreflective foci, moderate destruction of the ellipsoid zone and RPE), diabetic macular edema (neuroepithelium edema, intraretinal cystic cavities), epiretinal membrane What is optimal diabetic retinopathy screening frequency?
The screening frequency for diabetic retinopathy is tailored to diabetes type, disease stage, and risk factors:
Type 1 diabetes
- First screening: 3–5 years after diagnosis (due to onset in children and young adults)
- Then annually, if no DR is detected
- If DR is present, frequency depends on severity
Type 2 diabetes
- Screening at diagnosis, as DR may already be present.
- If no DR, repeat every 1–2 years.
Patients with confirmed DR
- No visible DR, mild non-proliferative diabetic retinopathy (NPDR), no DME — every 1–2 years
- Moderate NPDR — every 6–12 months.
- Severe NPDR — every 3 months.
- Proliferative DR (PDR) — monthly, with regular OCT monitoring of the macula.
- DME — monthly if center-involving, every 3 months if not.
Pregnant women with type 1 or type 2 diabetes
- Screening before conception or in the first trimester, with follow-up each trimester and postpartum
- Screening is not required for gestational diabetes without pre-existing diabetes
Post-treatment patients (laser or vitrectomy)
- Typically, every 3–6 months during the first year, individualized based on retinal stability

Diabetic retinopathy (hyperreflective foci, microaneurysms, destruction of the ellipsoid zone and RPE), diabetic macular edema (neuroepithelial swelling, intraretinal cystic cavities), epiretinal membrane. Monitoring of diabetic retinopathy progression
Ongoing diabetic retinopathy monitoring is essential to detect early signs of progression and guide treatment decisions. A key focus in monitoring is diabetic macular edema (DME), which represents fluid accumulation in the macula due to leakage from damaged retinal vessels. DME is a common complication of DR and the leading cause of vision loss in diabetic patients. OCT plays a central role in detecting DME and identifying structural changes that indicate disease progression.
OCT biomarkers in DME
OCT enables precise visualization of retinal layers with micron resolution, confirming DME presence and providing prognostic biomarkers for treatment selection and monitoring.
The main OCT biomarkers in DME include:
- Cystoid hyporeflective intraretinal spaces – usually in the inner nuclear layer (INL) or outer plexiform layer (OPL). Their number, size, and location correlate with edema severity. Large or confluent spaces may indicate chronicity and a worse prognosis.
- Subretinal fluid – accumulation between the neurosensory retina and retinal pigment epithelium. Often associated with a better visual prognosis, but requires close monitoring and consideration in anti-VEGF therapy.
- Central macular thickening – a key marker of treatment effectiveness and disease activity.

Diabetic retinopathy (hyperreflective foci, hard exudates), diabetic macular edema (neuroepithelial swelling, intraretinal cystic cavities). OCT red flags in DR progression
Beyond DME, OCT helps identify broader signs of DR worsening that require therapy reassessment:
- Progressive central macular thickening despite treatment
- Increase in intraretinal or subretinal fluid, or enlargement of cystoid spaces
- New hyperreflective foci, reflecting inflammatory activity (these may precede hard exudates or RPE changes)
- Development or progression of disorganization of inner retinal layers (DRIL), an independent predictor of poor prognosis, even when orphological improvement is seen on OCT
- Ellipsoid zone disruption, indicating photoreceptor damage
- Signs of macular ischemia, although better evaluated with OCTA, indirect signs on OCT may include thinning of the inner retinal layers.
- Tractional changes, such as epiretinal membranes, inner retinal stretching, or macular traction

Diabetic retinopathy (hyperreflective foci, hard exudates, destruction of the ellipsoid zone and RPE, disorganisation of the retinal inner layers (DRIL)), Diabetic macular edema (neuroepithelial swelling, intraretinal cystic cavities), subretinal fluid. The appearance of these OCT features should prompt clinicians to reconsider therapy, whether by switching anti-VEGF agents, introducing steroids, using combination therapy, or referring patients for surgical evaluation when traction is present.

Diabetic retinopathy (hyperreflective foci, hard exudates, destruction of the RPE), Diabetic macular edema (neuroepithelial swelling, intraretinal cystic cavities), subretinal fluid. What is the best treatment for diabetic retinopathy?
The treatment of diabetic retinopathy is based on a comprehensive approach that takes into account not only the disease stage, but also individual patient characteristics, OCT findings, comorbidities, and prognostic biomarkers. Modern strategies combine preventive, pharmacological, and surgical methods, as well as personalized medicine tools based on retinal imaging.
Criteria for treatment selection
The choice of therapy is guided by the following parameters:
- DR stage – non-proliferative, proliferative, with or without DME
- Form of macular edema – focal, diffuse, with or without subretinal fluid
- Presence of DRIL, EZ disruption, ischemic changes on OCTA
- Response to previous treatment – anti-VEGF, steroids, laser
- Comorbidities – renal insufficiency, hypertension, poor adherence
For low-risk patients, observation or focal laser may be sufficient. Patients with significant DME usually require anti-VEGF or steroid injections. Those with proliferative DR often undergo panretinal laser photocoagulation or vitrectomy.
Diabetic retinopathy treatment methods
The main treatment options for diabetic retinopathy include pharmacotherapy, laser therapy, surgical intervention, and personalized approaches based on OCT.
1. Pharmacotherapy: anti-VEGF and steroids
Anti-VEGF agents such as aflibercept, ranibizumab, and bevacizumab are the first-line therapy for diabetic macular edema. They are especially effective in patients with pronounced edema and without ischemia.
New drugs with extended duration of effect, including port delivery systems, are becoming available.
Steroids are used when DME is persistent, when patients do not respond to anti-VEGF therapy, or in cases with an inflammatory phenotype.
2. Laser therapy
Injections have largely replaced laser therapy in the treatment of DME. However, panretinal photocoagulation remains the standard treatment for proliferative DR.
Subthreshold micropulse laser is increasingly applied for focal edema, as it minimizes tissue damage.
3. Surgical treatment
Vitrectomy is recommended in cases of tractional macular edema, vitreous hemorrhage, or retinal detachment.
4. Personalization with OCT
Modern treatment protocols use OCT biomarkers to tailor therapy and improve prognosis.
Patient education and multidisciplinary care
DR treatment outcomes strongly depend on adherence. Patients must be informed about the need for regular injections, monitoring, and systemic control. Coordinated care involving ophthalmologists, endocrinologists, and family doctors helps maintain stable glycemic control and slows DR progression.
Diabetic retinopathy management: key takeaways
Diabetic retinopathy is a progressive disease, but modern diagnostics and treatments make it possible to preserve vision and improve outcomes. OCT and OCTA have become essential tools for early detection, risk assessment, and personalized therapy planning. Effective management combines pharmacotherapy, laser treatment, surgery, and patient education. Multidisciplinary care and strong patient adherence remain crucial for long-term success. With timely monitoring and tailored treatment, the progression of diabetic retinopathy can be significantly slowed.
Disclaimer: USA FDA 510(k) Class II; Altris Image Management System (Altris IMS); AI/ML models and components intended to use for research purposes only, not for clinical diagnosis purposes.
-
Altris Achieves MDSAP Certification, Strengthening Global Presence and Clinical Credibility
Altris Inc.
22.08.20251 min.22.08.2025
Altris Achieves MDSAP Certification, Strengthening Global Presence and Clinical Credibility
Altris Inc., a leading decision support platform for OCT scan analysis, proudly announces that it has passed the Medical Device Single Audit Program (MDSAP) audit.
Based on the objective evidence reviewed, this audit enables a recommendation for Initial certification to ISO 13485:2016 MDSAP, including the requirements of Australia, Brazil, Canada, the USA, and Japan, and EU 2017/745, and that the scope was reviewed and found to be appropriate for ISO 13485:2016/MDSAP and EU MDR 2017/745.
The results of this audit are suitable for obtaining the EU MDR 2017/745 certificate, which we are currently in the process of pursuing.
ISO 13485:2016/MDSAP enables Altris Inc. to “design, manufacture, and distribute medical software for the analysis and diagnosis of retinal conditions globally.” It is recognized by leading global health regulators and signals trust and credibility to public and private hospitals, eye care networks, and optometry chains worldwide.
MDSAP Certification also opens the door for Altris Inc. to enter new international markets, including Asia-Pacific, Latin America, and additional parts of North America. The MDSAP certification allows a single regulatory audit of Altris AI’s Quality Management System (QMS) to be recognized by multiple major health authorities, including:
- FDA (United States)
- Health Canada
- TGA (Australia)
- ANVISA (Brazil)
- MHLW/PMDA (Japan)
MDSAP enforces that the Quality Management System for developing, testing, and maintaining AI Decision Support for OCT complies with international medical device standards. Altris AI Decision Support for OCT Analysis system that facilitates the detection and monitoring of over 70 retinal pathologies and biomarkers, including early signs of glaucoma, diabetic retinopathy, and age-related macular degeneration.
“Achieving ISO 13485:2016 certification under the stringent MDSAP requirements is a significant accomplishment for our team,” said Maria Znamenska, MD, PhD, Chief Medical Officer at Altris AI. “As a practicing ophthalmologist, I understand that the safety of patients is the absolute priority. Especially when implementing such an innovative technology as AI for decision support in OCT analysis. That is why we did everything possible to build quality processes that guarantee the highest level of safety for the patients.
This certification enables Altris AI to expand its presence and offer eye care specialists upgraded functions such as GA progression monitoring, flags for smart patient filtering, or automated drusen count.”
“This is more than a regulatory milestone for our team – it’s a signal to the global eye care community that Altris AI is a trusted clinical partner,” said Andrey Kuropyatnyk, CEO of Altris AI.
About Altris
Founded in 2017, Altris AI is at the forefront of integrating artificial intelligence analysis into ophthalmology and optometry.
The company’s platform is designed to assist eye care professionals in interpreting OCT scans with greater objectivity and make informed treatment decisions. It’s a vendor-neutral platform compatible with OCT devices from 8 major global manufacturers. With a commitment to innovation and compliance, Altris AI continues to develop solutions that set higher standards in the eye care industry and improve patient outcomes.
Disclaimer: USA FDA 510(k) Class II; Altris Image Management System (Altris IMS); AI/ML models and components intended to use for research purposes only, not for clinical diagnosis purposes.
-
Glaucoma OCT Monitoring Guide: From Detection to Long-Term Care
Maria Znamenska
5 minGlaucoma OCT Monitoring Guide: From Detection to Long-Term Care
Table of Contents
- Glaucoma detection: why early diagnosis is critical
- How to detect glaucoma in early stages: key approaches
- Advanced imaging for glaucoma: OCTA
- OCT glaucoma monitoring after diagnosis
- Additional tools for monitoring glaucoma treatment
- Glaucoma OCT: the foundation of long-term glaucoma care
Optical Coherence Tomography (OCT) has fundamentally changed glaucoma diagnostics over the past two decades. It enables non-invasive, micron-level imaging of retinal microstructures and provides objective measurements of the retinal nerve fibre layer (RNFL), ganglion cell complex (GCC), and optic nerve head (ONH) parameters. Moreover, the advent of OCT angiography (OCTA) has introduced a new dimension in assessing microcirculation—complementing structural analysis and potentially predicting glaucoma progression.
Today, OCT is the standard for early detection, monitoring, and risk stratification of glaucoma progression, as recognised in international clinical guidelines. When combined with functional tests, tonometry, and anterior chamber angle assessment, OCT becomes the foundation for personalised glaucoma management.
Glaucoma detection: why early diagnosis is critical
Early glaucoma diagnosis is vital, as optic nerve damage caused by the disease is irreversible. Many patients seek care only after significant vision loss has occurred, at which point treatment may slow progression but cannot restore lost function. This is why ophthalmologists emphasise the importance of glaucoma detection at preclinical or pre-perimetric stages.
How does OCT help in early glaucoma detection?
OCT provides high-resolution imaging of the retina and optic nerve head. Unlike subjective functional tests, OCT delivers objective, quantitative data on ganglion cells, nerve fibre layers, and the neuroretinal rim, enabling recognition of even subtle structural changes.
Recent OCT models go further, allowing detailed visualisation of the lamina cribrosa, a structure known to be altered in glaucoma. Today, OCT is recognised as a key diagnostic tool in the guidelines of both the European Glaucoma Society and the American Academy of Ophthalmology.
How to detect glaucoma in early stages: key approaches
Early glaucoma detection relies on evaluating structural and functional parameters of the eye, supported by advanced imaging techniques. The three main parameters assessed with glaucoma OCT are:
- Ganglion Cell Complex (GCC) thickness and asymmetry
- Retinal Nerve Fibre Layer (RNFL) thickness
- Optic nerve head parameters with the DDLS scale
In addition, OCT Angiography (OCTA) provides complementary insights into ocular microvasculature that may indicate early glaucomatous damage.
Glaucoma detection parameter 1: GCC thickness and asymmetry
One of the most sensitive preclinical biomarkers of glaucomatous damage is thinning of the ganglion cell complex (GCC), which includes the ganglion cell layer (GCL), inner plexiform layer (IPL), and macular RNFL (mRNFL). It is assessed through macular OCT scans. Damage in this area is particularly critical, as 50–60% of all ganglion cells are concentrated within the central 6 mm zone.
Assessing asymmetry between the superior and inferior halves of the macula within the GCC is a key diagnostic indicator. Studies show that minimum GCC thickness and FLV/GLV indices (Focal Loss Volume / Global Loss Volume) are predictors of future RNFL thinning or emerging visual field defects. Asymmetry maps significantly ease clinical interpretation.
A newer approach—vector analysis of GCC loss—also allows clinicians to visualise the direction of damage, which often correlates with future visual field defects.

Glaucoma detection parameter 2: RNFL thickness analysis
RNFL analysis is among the most widely used glaucoma diagnostic methods. The RNFL reflects the axons of the ganglion cells and is readily measured in optic nerve scans. Temporal sectors are the most sensitive and often show the earliest changes.
Even when the overall thickness appears normal, localised defects should raise suspicion. Sectoral thinning of ≥5–7 μm is considered statistically significant. Age-related RNFL decline (~0.2–0.5 μm/year) must also be considered.
Glaucoma detection parameter 3: optic nerve head parameters and the DDLS scale
Evaluating the optic nerve head (ONH) is essential. OCT enables automated assessment of optic disc area, cup-to-disc ratio (C/D), cup volume, rim area, and the lamina cribrosa.
The Disc Damage Likelihood Scale (DDLS) classifies glaucomatous ONH changes based on the thinnest radial rim width or, if absent, the extent of rim loss. Unlike the C/D ratio, DDLS adjusts for disc size. When combined with OCT, DDLS significantly enhances objective clinical assessment.
In high myopia, automatic ONH segmentation often misclassifies anatomy. Here, newer deep learning–based segmentation models improve accuracy.

Advanced imaging for glaucoma: OCTA
OCT Angiography (OCTA), an advanced glaucoma OCT technique, provides unique insights into ocular circulation. It enables evaluation of:
- Vessel density in the peripapillary region
- Optic nerve and macular vascularisation
- Retinal versus ONH perfusion in both eyes

Studies confirm that reduced vessel density correlates with RNFL loss and visual field deterioration, and often precedes both.
OCT glaucoma monitoring after diagnosis
Glaucoma can progress even with stable intraocular pressure (IOP), making regular structural assessment of the optic nerve and inner retina crucial for therapy adjustment.
Glaucoma OCT is not only a diagnostic tool but also the primary method for monitoring glaucomatous damage. Unlike functional tests, OCT can detect even minimal RNFL or GCL thinning months or even years before visual field loss appears. With serial measurements and built-in analytics, OCT allows clinicians to track glaucoma progression rates and identify high-risk patients.
Methods for glaucoma progression monitoring
There are two main approaches to monitoring glaucoma progression with OCT:
Method 1: event-based analysis
This method compares current scans with a reference baseline, identifying whether RNFL or GCL thinning exceeds expected variability.
? Example: Heidelberg Eye Explorer (HEYEX) highlights suspicious areas in yellow (possible loss) or red (confirmed loss).
Limitations include sensitivity to artifacts, image misalignment, and segmentation quality. A high-quality baseline scan is essential.
Method 2: trend-based analysis
This approach accounts for time. The software plots RNFL/GCL thickness trends over time in selected sectors or globally and calculates the rate of progression.
Examples:
- RNFL thinning >1.0 μm/year is clinically significant.
- Thinning >1.5 μm/year indicates active progression.
It also accounts for age-related changes, helping differentiate physiological vs. pathological decline.
Visual assessment in glaucoma OCT
Qualitative analysis also plays an important role in detecting glaucoma progression. Key aspects include:
- Focal RNFL thinning (localised defects)
- Changes in the neuroretinal rim
- Alterations in ONH cupping
- GCL/GCIPL comparison (superior vs. inferior) on macular maps
- New segmentation artifacts (may mimic progression)

OCT glaucoma findings that indicate true progression
Five OCT findings suggest true glaucomatous progression:
- RNFL thinning >10 μm in one sector or >5 μm in several sectors
- New or worsening GCL asymmetry (yellow to red colour shift)
- Emerging or expanding RNFL defects on colour maps
- Increasing C/D ratio with concurrent rim thinning
- New localised areas of vessel density loss on OCTA
Particular attention should be paid to the inferotemporal and superotemporal RNFL sectors, where 80% of early changes occur.
Frequency of glaucoma OCT monitoring
According to the AAO and EGS, the recommended frequency for OCT glaucoma monitoring is:
- High-risk patients: every 6 months
- Stable patients: once a year
- For trend analysis: at least 6–8 scans over 2 years to ensure statistical reliability
Looking ahead, broader use of AI for glaucoma is expected to support earlier and more accurate detection, while also reducing false positives.
Additional tools for monitoring glaucoma treatment
While glaucoma OCT is essential for detecting structural changes, a comprehensive glaucoma assessment requires a multimodal approach. Additional tools include perimetry, tonometry, optic disc fundus photography, and gonioscopy.
Perimetry (visual field testing)
Functional assessment of the optic nerve remains crucial. Standard Automated Perimetry (SAP), most often performed with Humphrey Visual Field Analyzer protocols (24-2, 30-2, 10-2), is the most widely used method.
Key indices:
- MD (mean deviation): average deviation from normal values
- PSD (pattern standard deviation): highlights localised defects
- VFI (visual field index): summarises global visual function; useful for tracking glaucoma progression
- GHT (glaucoma hemifield test): automated analysis of field asymmetry
? Important: In 30–50% of cases, structural changes such as RNFL thinning on OCT precede visual field defects; in others, functional loss appears first. Best practice relies on integrated OCT and perimetry to correlate damage location and monitor glaucoma progression more precisely.
Combined OCT and perimetry remains the gold standard for progression monitoring.
Tonometry
Intraocular pressure (IOP) is the only clearly modifiable risk factor associated with both glaucoma onset and progression.
- Goldmann applanation tonometry remains the gold standard.
- A single IOP reading is insufficient — diurnal fluctuations are an independent risk factor, particularly in normal-tension glaucoma.
Optic disc fundus photography
Although subjective, fundus imaging remains valuable for documenting glaucomatous changes, especially in borderline cases. Unlike OCT, it does not provide quantitative data but helps visualise morphology over time.
What to assess:
- Progressive disc cupping
- Changes in neuroretinal rim shape or colour
- Disc margin haemorrhages (linked to faster RNFL thinning and visual field loss)
- Inter-eye comparisons
Gonioscopy
Gonioscopy evaluates the anterior chamber angle and helps exclude angle-closure, pigmentary, or pseudoexfoliative glaucoma. It also identifies:
- Neovascularisation
- Trabecular meshwork abnormalities
- Other angle anomalies
Patient education: a key to successful glaucoma management
Accurate glaucoma detection and therapy are not enough; adherence to monitoring and treatment is equally critical.
The challenge:
- Early-stage glaucoma is asymptomatic.
- Many patients underestimate its seriousness, leading to poor compliance, missed follow-ups, and discontinuation of therapy.
The goals of patient education:
- Explain that glaucoma progresses silently but can lead to irreversible blindness if untreated.
- Use real-life examples (before/after OCT scans, visual field comparisons) to illustrate progression.
- Teach patients to recognise warning signs (vision changes, eye pain).
- Visualise disease progression with AI tools showing RNFL loss and future risk.
Educational resources may include:
- Printed brochures in patient-friendly language
- Videos featuring OCT images with explanations
- Doctor–patient in-clinic discussions
- Telemedicine platforms with reminders and follow-up prompts
According to the AAO, patients who understand glaucoma are 2.5 times more likely to adhere to treatment and attend check-ups.
Glaucoma OCT: the foundation of long-term glaucoma care
Glaucoma OCT now plays a central role in both diagnosis and monitoring. Its ability to detect subtle structural changes before measurable functional loss makes early intervention possible and increases the chances of preserving vision.
But technology alone is not enough. Accurate interpretation, combined with strong patient education, is essential. When patients understand their disease and the role of glaucoma OCT in treatment, adherence improves and outcomes are better.
OCT is not just a diagnostic device; it is the cornerstone of an integrated glaucoma management strategy, from initial screening to long-term monitoring and treatment optimisation.
Disclaimer: USA FDA 510(k) Class II; Altris Image Management System (Altris IMS); AI/ML models and components intended to use for research purposes only, not for clinical diagnosis purposes.
-
Dry AMD Treatment: Modern Ways to Slow Progression
Maria Znamenska
5 min.Dry AMD Treatment: Modern Ways to Slow Progression
Table of Contents
- What are the dry macular degeneration treatment breakthroughs?
- How to monitor dry AMD progression with OCT?
- What are the challenges of dry age-related macular degeneration monitoring?
- How do I organize efficient dry AMD monitoring in my clinic?
- Why are optometrists on the front line of early AMD detection?
- How can OCT insights help support patients emotionally?
- Conclusion
For many years, dry or non-exudative AMD was seen as untreatable. Most research focused on wet AMD and anti-VEGF therapy.
Today, this paradigm is shifting. Around 30% of patients with age-related macular degeneration are affected by the dry form, which makes finding effective therapies critical. Recently, the first FDA-approved drugs for dry macular degeneration injections have appeared, offering hope to patients with geographic atrophy (GA). Alongside, new physiotherapeutic methods, such as multi-wavelength photobiomodulation, are showing promising results.
Geographic atrophy (GA) is an advanced, irreversible form of dry AMD. It occurs when parts of the retina undergo cell death, leading to progressive vision loss. But even the best dry AMD treatment is incomplete without objective measurement. That’s where modern tools for macular degeneration monitoring come in, and optical coherence tomography (OCT) is now at the core of this process.
What are the dry macular degeneration treatment breakthroughs?
The latest dry macular degeneration treatment breakthroughs include:
- Multiwavelength photobiomodulation
- FDA-approved injectable drugs
- AREDS 2-based supplements
In the past, recommendations focused only on reducing risks — quitting smoking, managing blood pressure, and eating a healthy diet.
Now, new approaches to dry AMD treatment combine prevention with active therapies to slow AMD progression and especially the advance of GA.1. Dry AMD treatment using multiwavelength photobiomodulation
Multiwavelength photobiomodulation for AMD is a promising new treatment. It uses specific red and near-infrared light wavelengths (~590–850 nm) and helps reduce oxidative stress, inflammation, and pigment epithelial cell death.
One of the best-known systems is Valeda Light Therapy, which delivers controlled multiwavelength light directly to the retina.
The LIGHTSITE III clinical trial showed that photobiomodulation can slow the decline in visual acuity and reduce the rate of GA expansion.
Limitations:
- Only 3–5 years of long-term data available
- Requires costly equipment and training
- Effectiveness in late-stage GA remains unclear

2. Dry AMD treatment using FDA-approved injectable drugs
AMD injection drugs approved by the FDA include Izervay and Syfovre.
- Izervay (avacincaptad pegol): A C5 complement protein inhibitor that targets the complement cascade involved in chronic retinal inflammation and damage. Izervay, approved for geographic atrophy secondary to dry AMD, has demonstrated a reduced rate of GA progression in clinical trials.
- Syfovre (pegcetacoplan): A C3 complement inhibitor that blocks the central component of the complement system to reduce inflammation. Syfovre is the first FDA-approved treatment for GA that targets complement component C3, showing a clinically meaningful slowing of GA progression.
Both dry macular degeneration injections have shown the ability to slow GA progression compared to placebo. Although they do not restore vision, slowing vision loss is a meaningful clinical outcome.
Key considerations for injections:
- Administered intravitreally, usually monthly or every other month
- Require doctor training and patient education on risks (e.g., endophthalmitis, increased intraocular pressure)
- Cost and access may limit use

3. Dry AMD treatment using AREDS 2-based supplements
AREDS 2 supplements are antioxidant supplements containing lutein, zeaxanthin, vitamins C and E, zinc, and copper. They can reduce the risk of progression to late-stage AMD by around 25% over five years, according to the AREDS 2 study.
Pros:
- Widely available
- Safe, with low side effect risk
- Supported by strong clinical evidence
Cons:
- Do not directly treat GA
- Cannot replace active therapies such as dry macular degeneration injections or photobiomodulation
How to monitor dry AMD progression with OCT
Effective macular degeneration monitoring relies on OCT. It is the gold standard for tracking retinal changes and predicting GA development.
Without OCT, clinicians are essentially “flying blind” when assessing AMD progression.Key monitoring parameters of AMD progression
The key monitoring parameters of AMD progression include GA area, drusen, and distance to fovea.
1. GA area
This is the main metric when using intravitreal eye injections. Modern OCT systems provide GA measurements in mm², allowing doctors to objectively track changes over time.
Even if patients don’t notice symptoms, a growing GA area signals disease progression. In FDA trials for Syfovre and Izervay, the GA area was the primary endpoint.
2. Drusen
Drusen vary in number, size, and shape. A reduction or disappearance of drusen on OCT may seem like an improvement, but could actually indicate a transition to the atrophic stage. Regular monitoring helps detect this early.
3. Distance to fovea
The closer GA is to the fovea, the greater the risk of sudden vision loss.
Early detection enables:
- Referral to an ophthalmologist
- Timely conversations about potential vision loss
OCT outputs for AMD progression monitoring and communication
Useful OCT outputs for AMD progression monitoring and communication are heat maps and progress charts.
1. Heat maps
Modern OCT systems use color-coded heat maps to show pigment epithelium thickness and drusen distribution. This visual format helps in several ways:
- Makes interpretation easier for clinicians
- Helps patients better understand their condition
- Encourages patients to stay engaged with treatment
In clinical practice, it serves as a highly effective communication tool.
2. Progress charts
Most OCT systems can compare results across visits
- For doctors: Helps guide treatment decisions
- For patients: Provides visual proof of stabilization or worsening
The role of objective evidence in patient treatment
Patients may question the value of long-term treatments or costly procedures.
OCT is the gold standard for patient motivation. When patients see actual changes, they’re more likely to agree to treatment.
What are the challenges of macular degeneration monitoring?
Monitoring dry AMD presents technical, organizational, and psychological challenges. Doctors of all levels of experience should be aware of them.
1. Invisible microchanges
Early atrophy or drusen changes may be subtle. Patients may not notice them due to eccentric fixation or slow adaptation.
Without OCT, doctors may miss early GA, delaying treatment.
It is necessary to perform OCT even when there are only minor changes in visual acuity or if the patient reports image distortion (metamorphopsia).
2. Subjective assessment
Ophthalmoscopy reveals only obvious changes. Subtle drusen or early atrophy might be missed.
Relying on patients’ complaints is risky — many don’t notice issues until it’s too late.
That’s why even small optical practices should establish clear referral pathways for OCT exams.
3. Unnecessary referrals
Optometrists or primary care doctors often refer patients to ophthalmologists “just in case,” because they don’t have access to OCT or lack experience interpreting it.
This puts unnecessary strain on specialists. In many cases, nothing new is done after the exam because there are no previous images for comparison.
4. Limitations of OCT devices
Not all OCT devices measure GA or track drusen equally well. Older models may lack automated measurements of atrophy area.
In some cases, referral to a center with advanced OCT is necessary.

How do I organize efficient dry AMD monitoring in my clinic?
Practical tips:
1. Create a baseline chart with OCT images during the first visit.
2. Monitor regularly:
- Every 6–12 months in the early stages
- Every 3–6 months with GA
- Before each intravitreal injection
3. Standardise scanning protocols to minimise variability.
4. Use OCT software tools for image comparison, GA calculation, heat maps.
5. Communicate clearly with patients about drusen, atrophy, and treatment goals.
Why are optometrists on the front line of early AMD detection?
Optometrists play a key role in spotting the early signs of AMD, as they are often the first point of contact in eye care.
They perform initial screenings, provide guidance on lifestyle and supplements, and ensure regular OCT monitoring.
If drusen, pigment epithelial changes, or signs of GA are present, they refer patients to ophthalmologists for confirmation and treatment planning.
How can OCT insights help support patients emotionally?
Patients with dry AMD often ask: “Why bother if it can’t be cured?”
Here, OCT plays an emotional as well as clinical role. Showing OCT scans can:- Prove the value of slowing AMD progression
- Emphasise patients’ role in preserving sight
- Reassure them that long-term care makes a difference
Dry macular degeneration treatment breakthroughs: key takeaways for slowing AMD progression
Modern dry macular degeneration treatment breakthroughs, including FDA-approved injections, photobiomodulation, and AREDS 2 supplements, have changed the outlook for patients.
Yet treatment alone is not enough. Without consistent macular degeneration monitoring using OCT, the benefits of these therapies may be lost.The future of dry AMD treatment lies in a partnership between optometrists, ophthalmologists, and patients. Together, with breakthrough therapies and precise monitoring, we can slow AMD progression and give patients the best chance of preserving vision.
Disclaimer: USA FDA 510(k) Class II; Altris Image Management System (Altris IMS); AI/ML models and components intended to use for research purposes only, not for clinical diagnosis purposes.
-
AItris for Buchanan Optometrists
Mark Braddon
3 min.Disclaimer: In the USA, Altris Image Management System (Altris IMS) has USA FDA 510(k) Class II clearance; AI/ML models and components are intended to use for research purposes only, not for clinical diagnosis purposes.
Buchanan Optometrists and Audiologists is no ordinary eye-care center.
The Association of Optometrists (AOP) estimates 17,500 registered optometrists working across roughly 6,000 practices in the UK. The UK Optician Awards recognise the best in the UK Optical industry. To even make the top 5 is our equivalent of an Oscar nomination! They are the only practice in the UK to consistently make the top 5 since 2008. Buchanan Optometrists describe themselves as innovators who “continually push boundaries.”
Their list of awards speaks for itself:
- 2012 – National Optician Award for Premium Lens Practice of the Year
- 2013 – Luxury Eyewear Retailer of the Year and Premium Lens Practice of the Year
- 2013 – Winner at the UK Optician Awards
- 2015–2016 – Best UK Independent Practice
- 2017–2018 – Optometrist of the Year, with Alisdair Buchanan named the top optometrist in the UK
- 2023–2024 – Best Independent Optician and Best Technology Practice
And this list is not finished, as Alisdair Buchanan, the Owner and the Director of the center, is investing in their growth continuously.

With a track record like this, it’s no surprise that Buchanan Optometrists was among the first to adopt AI for Decision Support in OCT. AI is rapidly becoming a vital part of modern eye care, and leading centers are already embracing it.
Mark Braddon, Altris AI VP of Clinical Sales, sat down with Alisdair Buchanan, the owner and director of the practice, to talk about his experience with AI and what it means for the future of optometry.
Mark Braddon: You’ve been working with OCT for years. What changed in your practice after bringing in Altris AI Decision Support for OCT?
Alisdair Buchanan, Owner: As someone already confident in interpreting scans, I didn’t need help understanding OCT—but Altris provides something even more valuable: a kind of second opinion. It supports my clinical decisions and offers an added layer of reassurance, particularly in borderline or complex cases. That’s not just helpful—it’s powerful.
I didn’t think our OCT assessments could improve much—until we started using Altris AI. It’s not just an upgrade; it’s become an indispensable part of delivering modern, high-quality eye care. Altris AI has significantly enhanced the way we interpret OCT scans. What used to require prolonged focus and cross-referencing now takes moments, without sacrificing accuracy or depth. The system analyses images with incredible precision, highlighting subtle pathological changes that are often time-consuming to detect, especially during a busy clinic day.

Mark Braddon: What was the first real benefit you noticed after bringing Altris AI into your day-to-day routine?
Alisdair Buchanan, Owner: One of the most immediate benefits has been in patient communication. The platform generates clear, colour-coded visuals that make explaining findings effortless. Instead of trying to talk patients through grainy greyscale images, we can now show them precisely what we’re seeing. It’s improved understanding, reduced anxiety, and increased trust in the care we’re providing.
Mark Braddon: Was it easy to fit AI Decision Support into your OCT workflow? How easy did you find integrating Altris AI?
Alisdair Buchanan, Owner: Integration was seamless—no faff, no friction. It fits naturally into our existing workflow, with scans uploaded and analysed within seconds. It’s helped us work more efficiently, without compromising the thoroughness our patients expect.
In short, Altris AI has sharpened our clinical edge and strengthened the service we offer. It doesn’t replace experience—it enhances it. And that, for me, is the real value.
Mark Braddon: In your experience, where has AI been the most helpful in clinical work?
Alisdair Buchanan, Owner: The main area where it shines is in picking up early macular changes, particularly dry AMD. Things like drusen or subtle changes in the outer retinal layers, which could easily be missed at a glance, are brought to the surface immediately.

It’s also been handy with diabetic patients. Just having that extra layer of input to flag microstructural changes helps us stay ahead of progression.
We’ve also started using it with glaucoma suspects. While our Heidelberg Spectralis remains our go-to for structural monitoring, having the RNFL analysis from Altris adds a checkpoint. I’d never base a referral purely on it, but it’s nice to have a second opinion—even if it’s an AI one.
Mark Braddon: Has AI Decision Support changed how you handle borderline or difficult-to-call cases?
Alisdair Buchanan, Owner: I’d say it’s given us more confidence, particularly in the grey areas—those borderline cases where you’re not quite sure if it’s time to refer or just monitor a bit more closely. With AMD, for example, it has helped us catch early signs of progression and refer patients before things become urgent.
And for glaucoma, again, it’s not replacing anything we do—it’s just another tool we can lean on. Sometimes it confirms what we already thought, and other times it nudges us to look again more carefully.
Mark Braddon: How has using AI impacted your conversations with patients during consultations?
Alisdair Buchanan, Owner: One of the unexpected benefits has been how much it helps with patient conversations. We show the scans on-screen during the consultation, and the colour overlays make things much easier to explain, especially with older patients. They can see what we’re talking about, which makes the whole thing feel more real and less abstract.
They often say, “Ah, now I understand,” or “So that’s what you’re looking at.” It’s not about dazzling them with tech—it just helps make the discussion more transparent and more reassuring.

Mark Braddon: Some professionals worry that AI might replace human judgment. How do you see its role in clinical decision-making?
Alisdair Buchanan, Owner: I don’t see Altris —or any AI—as a threat to what we do. It’s not here to replace us. We still make the decisions, take responsibility, and guide our patients. But it does help.
For me, it’s like having a quiet assistant in the background. It doesn’t get everything right, and I certainly wouldn’t act on it blindly—but it prompts me to pause, double-check, and sometimes spot something I might have missed otherwise. That can only be a good thing.
In short, Altris has sharpened our clinical edge and strengthened the service we offer. It doesn’t replace experience—it enhances it. And that, for me, is the real value.